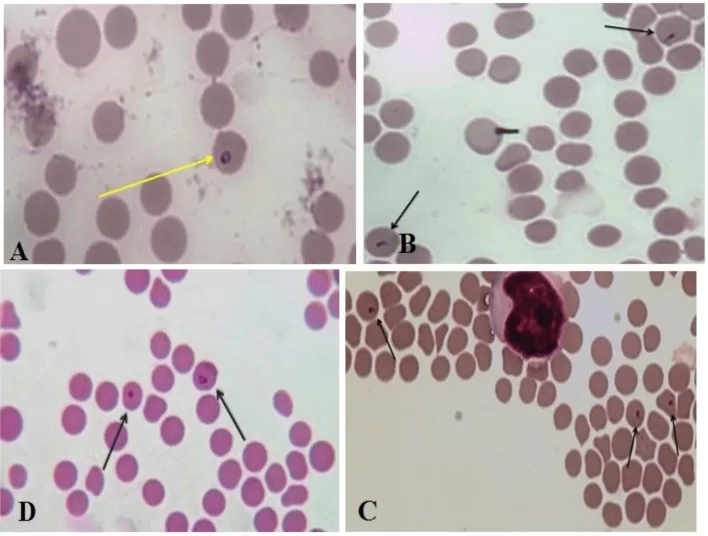

Theileria luwenshuni infections, an increasingly recognized medical concern, pose a significant threat to public health in regions like Yunnan Province, China. These piroplasmid parasites, related to both Babesia spp. in humans and other hemoparasite infections, are crucial to understand as they have been linked to severe clinical outcomes. Recent investigations revealed that among individuals presenting with febrile illnesses, a notable number tested positive for T. luwenshuni protozoa. With 13 confirmed cases identified through advanced molecular techniques, it’s evident that this pathogen is not only prevalent but demands urgent attention. The emergence of these infections highlights a growing need for public health initiatives to address the risks posed by these and other related parasites in endemic areas.
Infections caused by Theileria luwenshuni represent a subset of the ailing landscape of piroplasmid pathogens that impacts both livestock and human populations. Understanding the implications of T. luwenshuni within the context of emerging hemoparasite diseases is vital, especially when considering the concurrent threats posed by Babesia species. In regions such as southwestern China, particularly in the Yunnan Province, such parasites contribute significantly to the complex epidemiology of tick-borne diseases. As we delve into the implications of these infectious agents, the emphasis on effective monitoring and control strategies becomes more apparent, given their potential to disrupt public health infrastructures. The persistence of these infections necessitates a comprehensive approach to understanding and mitigating their impact on affected communities.
Understanding Theileria luwenshuni Infections and Their Impact
Theileria luwenshuni infections are gaining recognition as a significant concern in both veterinary and human health sectors, particularly in endemic regions like Yunnan Province, China. These protozoan parasites belong to the piroplasmid family, which also includes Babesia spp., another group of hemoparasites known for their pathogenic potential in humans and animals. The ability of T. luwenshuni to cause disease in humans, although less publicized than other hemoparasitic infections, warrants deeper investigation, given the rising incidence reported in recent studies.
As public health authorities focus on well-established pathogens such as Plasmodium, Theileria luwenshuni may slip under the radar despite demonstrating potential for human infection. Our research has shown that a notable percentage of individuals exhibiting symptoms like fever and anemia were positive for this pathogen. With the molecular detection of T. luwenshuni in ticks and livestock, there is an urgent need for vector-control strategies and health education initiatives to mitigate the threat posed by these infections.
The Role of Babesia spp. in Human Infections
Babesia spp., well-known piroplasmid parasites, are notorious for causing hemoparasite infections in humans, leading to potentially severe outcomes if not diagnosed and treated properly. In our examination of febrile patients from Yunnan Province, we identified several cases of babesiosis, revealing that B. microti and novel Babesia species are circulating in this region. This situation calls for heightened awareness among healthcare professionals, as symptoms of Babesia infections often overlap with those of more familiar diseases such as malaria.
Considering the climatic and ecological diversity of Yunnan Province, the vectors responsible for transmitting Babesia and Theileria parasites—primarily ticks—thrived in this setting, resulting in increased transmission risks. Understanding the dynamics of Babesia infections requires further research into their life cycle, hosting capability, and potential co-infections with organisms like T. luwenshuni. Public health initiatives must adapt to address these emerging threats, fostering a more comprehensive approach to managing hemoparasite infections.
Public Health Implications of Piroplasmid Parasites
The emergence of Theileria luwenshuni and Babesia spp. infections signifies critical public health challenges that need addressing in regions where these pathogens are prevalent. Given their zoonotic potential, hemoparasite infections pose a dual challenge to human and veterinary health, necessitating coordinated surveillance and prevention efforts. Investigating the transmission dynamics of these parasites is vital for understanding their impact on public health and agriculture, particularly in rural communities reliant on livestock.
With 3.3% of vector-host samples testing positive for genetically diverse Babesia species in our study, this highlights the necessity for improved diagnostics and public awareness strategies surrounding hemoparasite infections. Local populations at risk should be educated on preventive measures, including tick avoidance techniques and the recognition of symptoms that could indicate infection. By strengthening public health frameworks to encompass these piroplasmid parasites, we can better safeguard community health against these emerging diseases.
Investigating Hemoparasite Infections in Yunnan Province
Yunnan Province, characterized by its unique ecological conditions, serves as a hotspot for various vector-borne diseases, including those caused by hemoparasite infections. Our investigation into the potential infections among 1,721 individuals with symptoms like fever and anemia has underscored the urgent need to study the prevalence of piroplasmid parasites such as Theileria luwenshuni. These findings highlight the importance of molecular detection techniques that can reliably identify infections that may otherwise go unnoticed.
The significance of these infections within the context of public health cannot be understated. By mapping the incidence of hemoparasite diseases in Yunnan, health officials can better allocate resources and implement effective monitoring strategies. Furthermore, our discoveries surrounding the environmental reservoirs of these parasites provide critical insights that can guide proactive public health interventions aimed at reducing the risk of infection transmission to humans.
The Interaction of Theileria and Babesia Species
The interaction between Theileria luwenshuni and various Babesia species illustrates the complexities of piroplasmid parasites in their respective ecosystems. Co-infections are not uncommon, and the presence of these related pathogens in both human and animal hosts raises important questions about their transmission dynamics and effects on disease severity. Research that focuses on understanding how these species interact in shared environments is essential for developing comprehensive strategies for their management.
Given the pathogenic potential of both Theileria and Babesia, their studied coexistence in vectors and hosts highlights a critical area of study for infectious disease epidemiology. Our findings suggest that simultaneous presence in areas like Yunnan Province could lead to accentuated public health risks and complicate treatment protocols. This necessitates a call for further research into the environmental factors shaping their distribution and transmission, which can ultimately guide public health policies.
Novel Findings on Emerging Hemoparasite Diseases
Recent investigations have revealed alarming rates of hemoparasite infections in patients from Yunnan Province, particularly cases involving both Theileria luwenshuni and novel Babesia species. This emerging threat emphasizes the need for heightened awareness amongst healthcare providers regarding the potential for infectious diseases to arise from zoonotic pathogens. As such, distinguishing these infections from more commonly encountered diseases is critical in clinical settings.
The documentation of new strains of Babesia alongside T. luwenshuni reinforces the idea that regions like Yunnan are vital for understanding the epidemiology of piroplasmid parasites. The documented co-infection cases not only pose treatment challenges but also serve as a reminder of the interconnectedness of human, animal, and environmental health. Continued surveillance and research will be fundamental in safeguarding populations in Southwestern China against these public health threats.
Epidemiology of Theileria luwenshuni in the Region
The epidemiology of Theileria luwenshuni in Yunnan Province reveals critical insights into its transmission and prevalence among human populations. Recent studies indicate a growing recognition of human cases associated with this parasite, necessitating further epidemiological investigations. By continuously monitoring infection rates within local communities and assessing potential animal reservoirs, health authorities can formulate targeted interventions and contribute to controlling outbreaks.
As we analyze the transmission vectors and assess the genetic diversity among the parasites, it becomes clear that understanding T. luwenshuni’s behavior in the local ecological context is vital. This parasite’s adaptability to both animal and human hosts complicates control measures, emphasizing that comprehensive educational programs and community engagement strategies must accompany any public health response to mitigate risks effectively.
Environmental Factors Influencing Hemoparasite Infections
Environmental conditions greatly influence the dynamics of hemoparasite infections, including Theileria luwenshuni and Babesia spp. In Yunnan Province, the interplay between climate, habitat, and human activity creates an ideal setting for the vectors responsible for these diseases. Understanding how these environmental factors interact will be crucial for predicting outbreaks and developing effective intervention strategies.
For instance, shifts in land use and agricultural practices can impact tick populations and their infection rates, leading to increased transmission of piroplasmid parasites. Hence, a multi-faceted approach that considers environmental management alongside health initiatives will be pivotal in combating the rising incidence of hemoparasite infections in the region, providing a sustainable framework for public health.
Strategies for Managing Hemoparasite Threats
To manage the growing threat posed by hemoparasite infections like those from Theileria luwenshuni and Babesia spp., comprehensive strategies must be implemented. This involves not merely diagnosing and treating infections but also developing preventive measures aimed at reducing their incidence. Public health campaigns should focus on education regarding vector avoidance, proper livestock management, and the importance of early diagnosis.
Moreover, collaboration between healthcare sectors and agricultural practices is paramount. By fostering communication between veterinarians, medical professionals, and health officials, we can create an integrated approach for monitoring and responding to these emerging public health challenges. Ensuring that communities receive support and resources will enable them to effectively adapt and reduce the burden of hemoparasite infections.
Frequently Asked Questions
What are Theileria luwenshuni infections and how do they affect humans?
Theileria luwenshuni infections are caused by a protozoan parasite that primarily affects livestock but can also infect humans. These infections are part of a group known as piroplasmid parasites, which include other hemoparasites like Babesia spp. In humans, infections with Theileria luwenshuni have been identified, particularly in regions like Yunnan Province, China, highlighting their potential as public health threats.
How prevalent are Theileria luwenshuni infections in Yunnan Province?
In Yunnan Province, Theileria luwenshuni infections have been documented among individuals presenting with symptoms such as fever and anemia. A study revealed that 13 out of 1,721 individuals tested positive for T. luwenshuni, illustrating its endemic presence and the potential for hemoparasite infections in the region.
What role do piroplasmid parasites play in hemoparasite infections?
Piroplasmid parasites, including Theileria luwenshuni and various Babesia spp., are significant causative agents of hemoparasite infections. These parasites infect red blood cells, leading to conditions like anemia and fever. The prevalence of these parasites in livestock and their transmission through tick vectors highlight their importance in public health contexts.
Are Theileria luwenshuni infections similar to Babesia spp. infections?
Yes, Theileria luwenshuni infections share similarities with Babesia spp. infections as both belong to the group of piroplasmid parasites. They can cause similar symptoms in humans, including fever and anemia, and have been found co-existing in endemic regions such as Yunnan Province, China.
What public health threats do Theileria luwenshuni and Babesia spp. infections pose?
Theileria luwenshuni and Babesia spp. infections pose significant public health threats due to their ability to cause serious hematological conditions in humans. The rising number of cases reported, particularly in endemic regions like Yunnan Province, stresses the need for increased surveillance and awareness to manage and control these emerging hemoparasite infections.
How are Theileria luwenshuni infections diagnosed in humans?
The diagnosis of Theileria luwenshuni infections in humans typically involves molecular detection techniques, which identify the presence of the parasite’s DNA in blood samples. In a recent study, Western blot antibody analysis was also employed to confirm cases, ensuring accurate identification of this and other hemoparasite infections.
What is the significance of studying Theileria luwenshuni infections alongside Babesia spp. in humans?
Studying Theileria luwenshuni infections alongside Babesia spp. is crucial for understanding the full spectrum of hemoparasite infections in humans. This comprehensive approach addresses the overlapping epidemiology and clinical presentation of these piroplasmid parasites, aiding in better diagnosis, treatment, and public health strategies.
| Key Point | Details |
|---|---|
| Piroplasmid Parasites | Theileria luwenshuni and Babesia spp. are protozoan parasites affecting humans and animals. |
| Human Theileriosis | It is less studied compared to infections like Plasmodium and Babesia. |
| Study Population | 1,721 individuals with fever, anemia, or both from Yunnan Province. |
| Molecular Detection | 13 cases positive for T. luwenshuni identified; 5 confirmed by Western blot analysis. |
| Babesiosis Cases | 6 cases of babesiosis found, including 3 with B. microti and 3 with novel species. |
| Vector and Host Investigation | Presence of T. luwenshuni found in 1 tick and 53 livestock animals. |
| Emerging Public Health Issue | Endemic circulation of T. luwenshuni and Babesia spp. in southwestern China highlights their health significance. |
Summary
Theileria luwenshuni infections pose a significant public health threat as they are part of a group of piroplasmid parasites affecting both humans and animals. Recent studies conducted in Yunnan Province, China, have highlighted the prevalence of these infections among individuals with fever and anemia. The detection of T. luwenshuni and novel Babesia species calls for increased awareness and further research on their impact on health and the environment. As these parasites circulate endemically in southwestern China, addressing Theileria luwenshuni infections is essential for safeguarding public health and preventing future outbreaks.
The content provided on this blog (e.g., symptom descriptions, health tips, or general advice) is for informational purposes only and is not a substitute for professional medical advice, diagnosis, or treatment. Always seek the guidance of your physician or other qualified healthcare provider with any questions you may have regarding a medical condition. Never disregard professional medical advice or delay seeking it because of something you have read on this website. If you believe you may have a medical emergency, call your doctor or emergency services immediately. Reliance on any information provided by this blog is solely at your own risk.